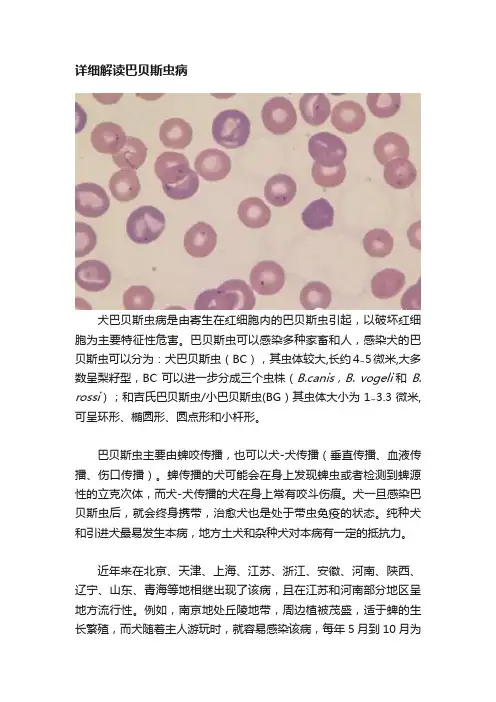

犬巴贝斯虫病的病因及症状
- 格式:docx
- 大小:14.85 KB
- 文档页数:1

中国动物保健2021.01投入高。
使用频率,可根据水线污染程度而设定。
4小结上述三种清理方式,每次结束后,都需要及时检查和监测消毒效果。
要检查乳头饮水器是否堵塞,防止个别笼内饮水器断水,造成应激诱发生产性能下降。
这七种方法,对于水线内部残留杂质、细菌、病毒和生物膜清理,都有不错的清理效果。
如若条件允许,可以采取多种组合方式进行,采取间歇性叠加使用,效果更好。
█1病原犬巴贝斯虫病是由犬巴贝斯虫、吉氏巴贝斯虫和韦氏巴贝斯虫寄生于犬的红细胞内所引起的血源性原虫病。
本文中所述吉氏巴贝斯虫虫体很小,长度1~2.5μm ,多呈环形,卵圆形,呈梨籽形的很少。
一个红细胞内最多可寄生30个虫体。
2流行病学犬的巴贝斯虫不仅寄生于患病犬体内,而且还长期寄生在带虫犬体内,生存时间长。
因此病犬、带虫犬和硬蜱是犬的巴贝斯虫病流行的病原来源。
犬吉氏巴贝斯虫必须经硬蜱传播,蜱传播犬吉氏巴贝斯虫的方式大多是经卵传播和刺叮传播。
本文中所说的吉氏巴贝斯虫的传播媒介有血红扇头蜱、二棘血蜱和长角血蜱三类。
3临床症状3.1临床检查一般呈慢性经过,患犬病初发热持续3~5d 后有5~10d 体温正常期,呈不规则回归热型。
精神沉郁,不愿意活动或四肢无力。
高度贫血,结膜苍白,一般不出现黄疸,食欲减退或废绝,急剧消瘦。
触诊脾脏肿大,肾(双侧或单侧)肿大疼痛。
尿呈暗褐色。
3.2病理变化除最急性没有明显病理变化外,其他可见内脏特别是肝、肾和骨髓充血;脾脏高度肿胀,脾髓呈暗蓝红色,坚实或中度软化。
胃肠黏膜苍白,或者部分区域呈轻度潮红和水肿;胆囊含有多量浓缩的黑绿色略呈屑粒状的胆汁;膀胱常有含血红蛋白的尿液;全身淋巴结肿胀;心外膜和心内膜下常有点状出血;腹腔表面脏器黄疸,慢性病黄疸变化不明显,而其他变化常更为显著,还有高度贫血的病变,体腔中聚有浆液。
4诊断要点4.1临床诊断病犬是否有遭到蜱叮咬的病史或在其体上抓到过蜱。
依据病犬遭蜱叮咬或抓到过蜱以及病犬出现的临床症状可以初步做出诊断。

详细解读巴贝斯虫病犬巴贝斯虫病是由寄生在红细胞内的巴贝斯虫引起,以破坏红细胞为主要特征性危害。
巴贝斯虫可以感染多种家畜和人,感染犬的巴贝斯虫可以分为:犬巴贝斯虫(BC),其虫体较大,长约4~5微米,大多数呈梨籽型,BC可以进一步分成三个虫株(B.canis,B. vogeli 和B. rossi);和吉氏巴贝斯虫/小巴贝斯虫(BG)其虫体大小为1~3.3微米,可呈环形、椭圆形、圆点形和小杆形。
巴贝斯虫主要由蜱咬传播,也可以犬-犬传播(垂直传播、血液传播、伤口传播)。
蜱传播的犬可能会在身上发现蜱虫或者检测到蜱源性的立克次体,而犬-犬传播的犬在身上常有咬斗伤痕。
犬一旦感染巴贝斯虫后,就会终身携带,治愈犬也是处于带虫免疫的状态。
纯种犬和引进犬最易发生本病,地方土犬和杂种犬对本病有一定的抵抗力。
近年来在北京、天津、上海、江苏、浙江、安徽、河南、陕西、辽宁、山东、青海等地相继出现了该病,且在江苏和河南部分地区呈地方流行性。
例如,南京地处丘陵地带,周边植被茂盛,适于蜱的生长繁殖,而犬随着主人游玩时,就容易感染该病,每年5月到10月为该地区的发病高峰期。
南京犬巴贝斯虫病的传播者主要是血红扇头蜱,感染的巴贝斯虫的种类BG:BC约为2:1。
据报道吉氏巴贝斯虫的潜伏期是7-21天,犬巴贝斯虫为10-21天,也与个体免疫力有关。
感染包括超急性、急性、慢性和亚临床型,急性病例可导致死亡。
其中,吉氏巴贝斯虫(BG)病常呈慢性感染,表现亚临床症状。
犬巴贝斯虫病(BC)则可引起轻度至重度疾病。
临床症状沉郁嗜睡、发热、贫血、黄疸、血红蛋白尿、肝脾肿大、消瘦虚弱,急性病例可导致死亡。
如病犬能耐过,则贫血可在3-6周后逐渐消失,犬体康复,耐过的病犬有带虫免疫现象。
病理变化溶血性贫血(血管内和血管外溶血)、血小板减少血症(可能是免疫介导性)、组织缺氧损伤中枢神经系统、肾和肌肉等组织器官。
当出现严重贫血时,大多主要是免疫性溶血性贫血,Coombs测试呈阳性。

犬巴贝斯虫病怎么治疗犬巴贝斯虫病对狗有很大的伤害,那应该怎样去治疗预防呢下面是店铺为你整理的犬巴贝斯虫病的治疗方法,一起来看看吧!犬巴贝斯虫病的症状病犬高热,黄疸而且有呼吸困难的现象,有些病犬脾脏肿大,触之敏感。
尿中出现蛋白质,可能会有血红蛋白。
常呈慢性经过,只在发病早期呈现间歇热现象。
染病的犬通常高度贫血,但无黄疽。
在食欲状态良好的同时,身体却有高度消瘦的现象,尿液中含有血红蛋白和蛋白质。
如果病犬能够在病中不死亡,则该病在3-6个月后即可痊愈。
犬巴贝斯虫病的原因1、犬巴贝斯虫:犬巴贝斯虫虫体较大,一般长4~5微米,最长可达7微米。
典型虫体为梨籽形,两虫尖端以锐角相连,每个红细胞内的虫体数目为1~16个。
2、吉氏巴贝斯虫:吉氏巴贝斯虫虫体很小,多呈环形,呈梨籽形的很少,每个红细胞内最多可寄生15个虫体。
犬巴贝斯虫病的诊断方法(1)流行病学调查:当地是否有传播本病的蜱,当时是否为蜱的活动季节。
病犬是否有遭到蜱叮咬的病史或在其体上抓到过蜱。
(2)临床症状:犬巴贝斯虫病,主要表现为高热,黄疸,呼吸困难。
有些病犬脾脏肿大,触之敏感。
尿中含蛋白质,间或含血红蛋白。
吉氏巴贝斯虫病常呈慢性经过,仅病初发热或为间歇热。
病犬高度贫血,但无黄疽。
虽食欲良好,却高度消瘦,尿含蛋白质或兼有微量的血红蛋白。
病犬常死于衰竭。
如能耐过,则于3~6周后贫血逐渐消失而康复。
(3)实验室检查:采病犬耳尖血作涂片,姬氏液染色后检查,如发现典型虫体即可确诊。
犬巴贝斯虫病的传播及预防1、犬巴贝斯虫:犬巴贝斯虫的传播媒介为血红扇头蜱、边缘革蜱、网纹革蜱、美丽革蜱、李氏血蜱和铅色璃眼蜱。
2、吉氏巴贝斯虫:吉氏巴贝斯虫的传播媒介为血红扇头蜱、二棘血蜱和长角血蜱。
1、在疫区要做好犬体的防蜱灭蜱工作,可应用杀虫药,如25ppm溴氰菊酯溶液,每隔7~10天喷淋1次犬体。
2、对病犬应做到早发现,早诊断,早治疗。
发现病例后,可应用三氮脒、咪唑苯脲的治疗剂量对其他健康犬进行药物预防,并防止犬捕食啮齿类动物,防止猫粪污染饲料及饮水。

宠物寄生虫的症状以及治疗
犬血液原虫(巴贝斯虫病)病原为巴贝斯属的犬巴贝斯虫(B.canis),感染犬、狼、豺、狐等,寄生于红细胞内。
分布于美洲、南欧、前苏联、亚洲、非洲等地。
病原为大型虫体。
常见成对的梨子形虫体,阿米巴形虫体一般有数个空泡。
传播媒介有血红扇头蜱、网纹革蜱、李氏血蜱。
安氏革蜱和边缘璃眼蜱,可以实验性传递。
病原致病力强,可引起犬的发病和死亡。
临床症状主要表现为,外来犬感染本种有的呈急性型,发病后1~2天内死亡,临床上无明显症状,但本病一般呈慢性经过。
病初精神沉郁,喜卧厌动。
体温升到40~41度,持续3~5天,经一段正常期后又升温,呈不规则的间歇热型。
病犬呈现渐进性贫血,结膜和粘膜苍白,轻度黄染。
随着病程的发展,食欲废绝,卧地不起,营养不良,明显消瘦,心跳和呼吸加快。
触诊肝、脾肿大。
尿呈现红褐色,有的会出现血尿。
诊断应结合流行病学资料、症状、病原体检查综合做出。
虫体检查一般是采血涂片经染色后镜检,发现虫体即可确诊。
也可以免疫学方法进行辅助诊断。
治疗可用锥黄素、三氮脒、咪唑苯脲等。
预防的关键在于灭蜱和防止蜱叮咬动物。
除常规方法预防外,咪唑苯脲缓释注射液可收到良好的预防效果。

犬巴贝斯虫病的诊断与防治作者:陈达雷来源:《农家科技下旬刊》2014年第09期犬巴贝斯虫是一种经蜱传播、在犬体内单个或成对寄生于红细胞内,引起严重贫血和血红蛋白尿症的一种严重的寄生原虫病。
从统计情况看,寄生于犬的虫种有犬巴贝斯虫、吉氏巴贝斯虫、韦氏巴贝斯虫。
我国流行的主要虫种为犬巴贝斯虫、吉氏巴贝斯虫。
一、病原形态(一)吉氏巴贝斯虫吉氏巴贝斯虫为小型虫体,多见于红细胞的边缘或偏中央,呈环形、椭圆形、原点形、小杆形,偶尔也可见成对的小梨子形虫体。
在一个红细胞内可寄生的虫体以1~2个为多。
(二)犬巴贝斯虫犬巴贝斯虫为大型虫体,虫体长度常大于红细胞半径,典型虫体呈梨子形,也有似变形虫、环形等多种形状的虫体。
一个红细胞内可以感染多个虫体,多的可达到16个。
二、流行特点本病的流行取决于病原体、传播媒介和易感动物(犬)三个方面的因素。
(一)犬巴贝斯虫病与一般的寄生虫病在发病日龄上相反,一般的寄生虫病对幼犬危害严重,而该病对幼犬的危害较轻。
出现这种情况的主要原因是,幼犬可以从初乳中获得被动免疫,因此感染后只表现出轻微症状。
如果带虫犬此后不断受到感染,机体处于带虫免疫状态,不出现临床症状。
但是如果有其他诱因导致机体抵抗力下降时可以发病。
(二)在非流行区,犬群体免疫水平较低,幼犬得不到初乳的保护,如果突然从流行区引入发病犬或者带虫犬,可能出现爆发性流行。
(三)该病对良种犬如军犬、警犬和猎犬危害极大。
三、致病机制犬巴贝斯虫病的致病作用主要表现在对红细胞的破坏上。
虫体的寄生和繁殖会造成红细胞的大量破坏,发生溶血性贫血,结膜出现苍白黄染;加之虫体毒素及其代谢产物在体内蓄积,可作用于神经系统,导致机体出现间歇热、四肢无力、身体摇摆。
随着病情的加重,患病犬最终会因为严重的营养不良、溶血、贫血、缺氧和中毒而死亡。
四、症状犬感染犬巴贝斯虫、吉氏巴贝斯虫后潜伏期不同。
自然感染犬巴贝斯虫为 10~21天,感染吉氏巴贝斯虫为14~28天。


病例2 巴贝斯虫病类宠物信息:犬中华田原公 4岁主诉:该犬昨天在警犬所就诊为巴贝斯虫病,昨天输血治疗检查:该犬精神一般,时有流涎,有食欲,大便黄而成型,小便暗黄中带红。
黄疸,贫血状况严重(口色苍白)。
听诊心率 96次/分,体温 39.4℃听诊心率 96次/分,体温 39.4℃治疗原则:应用三氮脒(贝尼尔、血虫净)特效药物;对症治疗:针对严重贫血情况进行大量输血;使用广谱抗生素防止继发或并发感染;补充大量体液、糖类及维生素,预防严重脱水及衰竭。
若出现黄疸和并发肝损伤时,要使用保肝药物。
血常规检验结果:编号检验项目名称结果参考范围1 RBC(M/μl) 红细胞 4.6↓ 5.50-8.502 HCT(%) 红细胞压积35↓37.0-55.03 HGB(g/dl) 血红蛋白10.3↓12.3-18.04 MCV(fL) 红细胞平均体积64 60.0-77.05 MCH(pg) 平均血球血红素21.7 18.5-30.06 MCHC(g/dl) 平均血球血红素浓度37.3 30.0-37.57 RDW(%) 红细胞分布宽度29↑14.7-17.98 %RETICI(%) 网织红细胞百分数/ 0-19 RETICI(K/μl) 网织红细胞数/ 5-8510 WBC(K/μl) 白细胞8.0 5.50-16.911 %NEU(%) 中性粒细胞百分数89.5 60-8012 %LYM(%)淋巴细胞百分数23.94 12.0-30.013 %MONO(%) 单核细胞百分数 6.73 3.0-15.014 NEU(K/μl) 中性粒细胞数7.8 2.00-12.0015 LYM(K/μl) 淋巴细胞数 1.85 0.50-4.9016 MONO(K/μl) 单核细胞数0.54 0.30-2.0017 PLT(K/μl) 血小板数185 175-500镜检:可见极个别犬巴贝斯虫Rp①氨苄0.5g×1地米5g× 1生理盐水100ml×1/iv用法:将以上药品,一次静脉滴注,每日一次0.5×2② VC50% G 20×1(10ml)复方生理盐水 100ml×1/iv用法:将以上药品,一次静脉滴注,每日一次。

犬猫巴贝斯虫病的诊治葛海燕(内蒙古农业大学职业技术学院014100)摘要:巴贝斯虫病是由巴贝斯虫感染引起的一种血源性的原虫病,一旦发生具有较高的死亡率。
本文就犬猫巴贝斯虫病的诊治进行具体的介绍,希望能够为同行提供参考。
关键词:犬猫;巴贝斯虫病;诊治巴贝斯虫病是由以蜱为媒介的巴贝斯虫感染引起的一种血源性的原虫病。
该病不仅发病急、病程较短同时死亡率较高,目前广泛分布于全国各地,在有蜱滋生的地方均可发生,近年来该病呈现出流行以及暴发的趋势。
由于家养宠物犬以及猫经常在草地以及山地牵遛,因而其感染率较高,待主人能够发现临床症状时,病情已经较为严重,或者已经产生了严重的并发症。
本文就犬猫巴贝斯虫病的诊治进行具体的介绍,希望能够为同行提供参考。
1临床症状1.1犬巴贝斯虫病病犬患病初期精神委靡,体温升高至40℃以上并呈现间歇热,食欲不振甚至不食,呼吸困难,脉搏加快,可视黏膜由苍白变至黄染。
尿液颜色为黄色,有时可以看到血红蛋白尿。
一些病犬会出现呕吐的症状,眼内存在大量的黏性分泌物。
病犬脾脏肿大,单侧或者双侧肾脏肿大并且存在明显的痛感。
此外,该病极有可能导致神经症状、急性肾功能衰竭、急性呼吸道窘迫综合症、免疫介导性贫血、以及血液黏稠、低血压、胰腺炎等并发症。
1.2猫巴贝斯虫病在自然条件下,猫巴贝斯虫病主要发生于2岁以下的猫。
病猫主要表现为精神委靡、体重减轻、食欲不振、毛色暗淡无光、贫血、虚弱以及腹泻。
一些病猫会出现非正常的发热以及黄疸,出现异食癖、呕吐以及呼吸道症状。
该病常因临床症状不明显而错过了最佳治疗时期。
2实验室检查2.1血液学检查对病畜的血液进行观察,其血液较为稀薄,血沉加快,凝固不佳,上层血浆的颜色为黄色。
红细胞大小各异,颜色较浅。
白细胞数量明显增加,通常在8.5×109个/L -12.8×109个/L 之间;红细胞的数量明显下降,通常为1.9×1012个/L -3.5×1012个/L ;此外,血小板总数以及血红蛋白含量明显减少。
犬巴贝斯虫病(Dogswithbabesiosis)一、概述犬巴贝斯虫病(Dogs with babesiosis)又俗称为犬焦虫病,是由巴贝斯虫引起的、由蜱虫作为传播媒介的犬血液性原虫病,幼犬较成年犬易感染,非疫区的犬进入疫区后更容易感染。
该病的严重程度取决于巴贝斯虫的种类及受感染犬的免疫反应。
二、流行病学㈠、病原及生活史1、病原目前在中国(主要在河南、江苏及湖北等部分地区呈地方性流行),临床上最常见的感染犬的巴贝斯虫包括吉氏巴贝斯虫(Babesia gibsoni,1-2.5μm)和犬巴贝斯虫(Babesia canis,4-7μm)。
感染犬的巴贝斯虫属于原生动物门(Protozoa)、顶复动物亚门(Apicomplexa)孢子虫纲(Sporozoasida/Sporozoa)、梨浆虫亚纲/焦虫亚纲(Piroplasmia)、梨浆虫目/焦虫目(Piroplasmida)、巴贝斯科(Babesiidae)、巴贝斯属(Babesia)。
2、巴贝斯虫的生活史巴贝斯虫的生活史比较复杂,在发育过程中,需转换2个宿主。
⑴、蜱虫摄入巴贝斯虫后,巴贝斯虫会先在蜱虫体内进性有性繁殖(配子生殖),之后再进行无性繁殖(通常是分裂生殖,但大部分情况下是孢子生殖),进而导致在蜱虫的唾液腺内产生大量感染脊椎动物宿主的的巴贝斯虫孢子体。
⑵、当犬被携带巴贝斯虫的蜱虫叮咬后,蜱虫会经唾液将唾液腺内的巴贝斯虫孢子体释放到犬的血液内。
进入犬血液内的巴贝斯虫孢子体会先附着在红细胞表面,后侵入到红细胞内并进行分裂生殖,形成裂殖体并最终形成裂殖子释放出红细胞,释放出的裂殖子将继续入侵其它红细胞进行分裂生殖。
㈡、传播途径1、蜱虫是巴贝斯虫的中间宿主,经蜱虫叮咬是巴贝斯虫最常见的传播途径。
常见的导致犬感染巴贝斯虫的蜱虫一般为硬蜱,其生活史分为卵(egg)、若虫(larvae )、幼虫(nymph)及成虫(adult)四个周期;90%的硬蜱为三宿主蜱。
吉氏巴贝斯虫虫体很小,多呈椭圆形、环形、圆点形、小杆形,偶见梨籽形。
犬的每个红细胞内可寄生15个虫体。
患犬常呈慢性经过,病初其体温升高到39.5℃,持续3~5d后体温转正常,5~7d后体温再次升高,呈不规则的间歇热。
病犬精神沉郁,不愿活动或活动时四肢无力,高度贫血,结膜苍白,有的黄染,食欲减退或废绝,尿呈黄色或暗褐色。
有的犬脾脏肿大,肾肿大,偶见消瘦,有腹水、支气管炎等。
6个月以内的犬易感染该病,其症状较轻,死亡少。
该病成年犬发病率低,但病情较重,死亡率较高。
犬吉氏巴贝斯虫病主要发生在4~7月,炎热季节为本病的高发期。
病愈犬有带虫免疫现象,可保持带虫免疫2~4年,但其免疫力低,治疗不及时等原因可造成复发。
此病具有明显的地方性和季节性特点。
1典型病例1.1病犬1泰迪,3岁,雌性,3kg,已正常免疫。
该犬精神不振,食欲差,呼吸加重,消瘦,尿呈暗褐色,其左前肢曾发现数个大小不等的蜱。
病犬体温39.3℃,脉搏100次/min,呼吸35次/min,背毛杂乱,鼻尖干裂,可视黏膜苍白。
1.2病犬2边境牧羊犬,9个月,雌性,12.4kg,已免疫。
该犬精神不振,无力,食欲较差,消瘦,曾在其颈部发现蜱虫。
病犬体温39.8℃,脉搏110次/min,呼吸33次/min,可视黏膜苍白,背毛杂乱,鼻尖干裂。
2临床诊断2.1流行病学两例病犬均有被蜱虫叮咬的病史。
吉氏巴贝斯虫的传播媒介为血红扇头蜱、二棘血蜱和长角血蜱。
吉氏巴贝斯虫可经卵传递,也可经变态阶段传递。
2.2实验室诊断2.2.1血常规检查病犬1白细胞、淋巴细胞、单核细胞值同时上升,红细胞、血红蛋白、红细胞比溶同时下降,病犬2以上指标同病犬1,且其血小板值下降。
据此诊断犬1、犬2均为严重的红细胞性低色素性贫血,并严重感染。
血常规检查结果见表1。
2.2.2生化检查病犬1、病犬2总胆红素含量增加,表明红细胞死亡数增加。
生化检查结果见表2。
许芸1,王世伟2(1.新疆农业职业技术学院,新疆昌吉831100;2.乌鲁木齐正大有限公司,新疆乌鲁木齐830022)中图分类号:S829.259文献标识码:C文章编号:1001-8964(2021)05-0048-02收稿日期:2021-03-22482.2.3血液涂片检查病犬1及病犬2血液涂片瑞氏染色,镜检,结果均在红细胞内发现染成淡蓝色的小梨籽形虫体,其呈圆形、环形和逗点形等,虫体的染色质团呈紫红色。
关于犬巴贝斯虫病在遛狗的过程中如果狗狗喜欢去草丛或者一些灌木林中,就很可能会被蜱虫咬到,而蜱虫作为一种体外寄生虫,其实也会传播一些其他的疾病,其中犬的巴贝斯虫病就是一种由蜱作为传播媒介的一种血液寄生性原虫病。
相信很多主人对于体外驱虫已经蜱虫都有知道或有一定了解,但是对于巴贝斯虫却很少有听到,以至于有些主人会以为得了蜱虫灭蜱就可以了,其实不然。
狗狗寄生于犬的巴贝斯虫(以前也叫巴贝斯焦虫)有两种:犬巴贝斯虫和吉氏巴贝斯虫。
主要寄生于犬的红细胞中,主要导致机体贫血和血红蛋白缺乏,是犬的一种严重的原虫病。
巴贝斯虫的生活史必须要通过两个宿主来完成,而目前研究的结果是蜱虫是唯一其所知的终末宿主。
其发育共要经历三个阶段,其中包括:裂殖生殖,配子生殖,孢子生殖。
细胞图裂殖生殖:巴贝斯虫随蜱的唾液进入机体,然后寄生于红细胞中,并在红细胞内进行繁殖,这时进行的是无性繁殖,包括:二分裂生殖,由木头一分为二;出芽生殖或产生母体先产生一个小的芽,然后这个小芽继续长大成熟后即和母体分开。
配子生殖:这个阶段进行的是有性生殖,巴贝斯虫随蜱的叮咬进入到蜱虫的肠管内,大部分死亡,小部分发育成辐射体(纺锤形的具有鞭毛突起)。
这个辐射体就是配子,当两个相似的辐射体结合后便形成合子。
孢子生殖:合子进入蜱的器官反复分裂后进入到雌蜱的卵母细胞,经子代蜱发育成熟和采食时进入唾液腺,并在唾液腺内进行孢子生殖。
蜱吸血时又将子孢子传给动物。
由巴贝斯虫的生活史我们知道,其跟蜱虫有很大的联系,所以临床发病也基本都有过蜱虫的感染史。
其发病也与蜱虫的活动时间已经活动范围相关!巴贝斯虫的危害:1、寄生于红细胞内,并在其内繁殖,破坏红细胞,导致溶血性贫血并引起黄疸(可视黏膜发黄)。
2、由于红细胞大量溶解,使得机体运氧能力下降,机体供养不足而出现呼吸困难,全身代谢障碍和酸碱电解失衡,因而对多种组织器官造成损伤。
3、巴贝斯虫体具有酶的作用,使动物血液中出现大量扩血管活性物质,如激肽释放酶,血管活性肽等,导致低血压性休克综合症。
三、犬巴贝斯虫病引起犬巴贝斯虫病的病原体有3种:犬巴贝斯虫(B. canis)、吉氏巴贝斯虫(B. gibsoni)和韦氏巴贝斯虫(B. vitalii),我国已报道的为吉氏巴贝斯虫。
其主要症状为贫血、黄疸和血红蛋白尿。
对良种犬,尤其是军犬、警犬和猎犬危害严重。
犬巴贝斯虫和吉氏巴贝斯虫均为世界性分布的血液原虫,前者较后者分布更为广泛,吉氏巴贝斯虫主要分布于亚洲,在我国江苏、河南的部分地区呈地方性流行。
病原(1)吉氏巴贝斯虫。
虫体很小,多位于红细胞边缘或偏中央,呈环形、椭圆形、圆点形、小杆形,偶尔可见十字架形的四分裂虫体或成对的小梨籽形虫体,以圆点形、环形及小杆形最为多见(图15-8)。
圆点形虫体为1团染色质,用姬氏法染色呈深紫色,多见于感染的初期。
环形虫体为浅蓝色的细胞质包围1个空泡,带有1团或2团染色质,位于细胞质的一端,虫体小于红细胞直径的1/8。
偶尔可见大于红细胞半径的椭圆形虫体。
小杆形虫体的染色质位于两端,染色较深,中间细胞质着色较浅,呈巴氏杆菌样。
在1个红细胞内可寄生1~13个虫体,以寄生1~2个虫体多见。
(2)犬巴贝斯虫。
虫体很大,最长的可达7μm。
在红细胞中多呈双梨籽形排列,2个虫体的尖端以锐角相连。
在红细胞的虫体数目较多,有点可多达16个。
(3)韦氏巴贝斯虫。
多呈圆形、卵圆形和梨籽形,比犬巴贝斯虫小,直径2~4μm。
也有人认为它是犬巴贝斯虫的1个虫株。
流行病学吉氏巴贝斯虫传播者为长角血蜱、镰形扇头蜱、血红扇头蜱,以经卵传播或期间传播的方式传播。
犬巴贝斯虫的传播者为李氏血蜱、血红扇头蜱、蓖子硬蜱、网纹革蜱和安氏革蜱。
症状吉氏巴贝斯虫病常呈慢性经过。
病初精神沉郁,喜卧厌动,活动时四肢无力,身躯摇晃。
体温升高至40~41℃,持续3~5天后,有5~10天体温正常期,呈不规则间歇热型。
渐进性贫血,结膜和黏膜苍白;食欲减少或废绝,营养不良,明显消瘦。
触诊脾脏肿大;肾(单侧或双侧)肿大且疼痛;尿呈黄色至暗紫色,少数病犬有血尿。
犬巴贝斯虫病的病因及症状
边境牧羊犬(详情介绍)
对于犬巴贝斯虫病大家可能并不是很熟悉,的确该病在平时并不是十分常见,其实这种病是由犬巴贝斯虫或吉氏巴贝斯虫引起的由蜱虫传播的血液寄生虫病。
我们就先来对犬巴贝斯虫病的病因及症状做一下描述,希望对大家能有所帮助。
病因:本病由硬蟀传播。
一旦感染,巴贝斯虫就会在红细胞内繁殖。
该病还怀疑可经胎盘传播,且与幼犬的衰弱综合征有关。
症状描述:急性发作,贫血,伴随发热和呆滞,是最常见的特征性症状。
慢性感染不常见,而且没有特征性症状。
伴随低血压休克和缺氧的急性发作性巴贝斯虫病,可能导致死亡。
另外,还能观察到溶血性贫血,血小板减少,淋巴结肿大和脾肿大。
其他各种各样的临床症状,因感染的组织不同而不同。
轻度到严重的肺病、呕吐、腹泻、溃疡性口腔炎、严重的大出血、肌炎和横纹肌溶解,以及中枢神经系统症状都有所报道。
疾病诊断:巴贝斯虫病应重点与感染犬免疫介导性溶血性贫血和血小板减少症鉴别诊断。
但是,也应考虑患犬是否感染由蜱传播的其他疾病,如埃里克氏体病、落基山斑疹热。